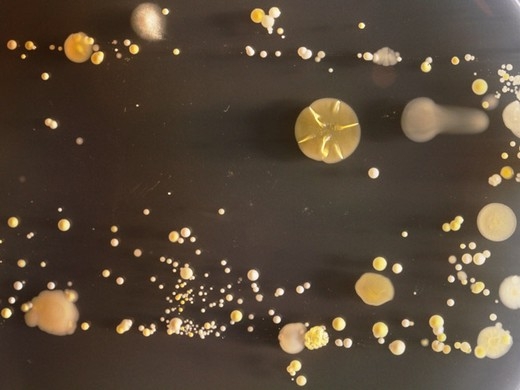

Bu Bakteriler Cep Telefonunda Yaşıyorlar
25 Temmuz 2015 Cumartesi 12:12Bu bakteri, "Hastane infeksiyonu" olarak adlandırılıyor. Akıllı telefonların klavye ve benzeri bir dizi tuşa sahip olması, daha çok bakteri taşımalarına neden oluyor. Eski tip telefonlar bu nedenle daha az pis olabilir.
Tüm Hakları Saklıdır © 2014 Haberdarım | İzinsiz ve kaynak gösterilmeden yayınlanamaz.
Haber Yazılımı: So Bilişim
Haber Yazılımı: So Bilişim